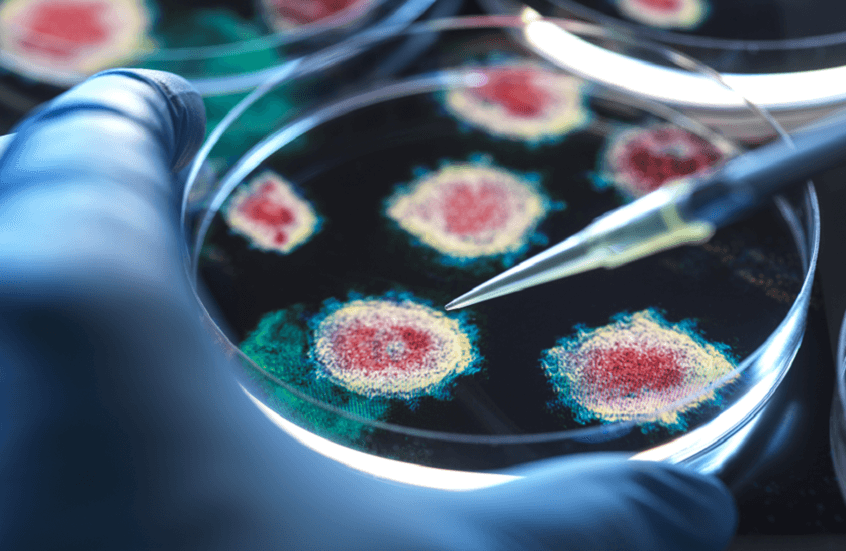

دراسة مقلقة.. قنابل فيروسية مهملة قد تهدد الصحة العالمية
حذّر فريق من الباحثين في مجال الأمراض المعدية من خطر فيروسين ناشئين من أصل حيواني.
وأكد الباحثون أن فيروس الإنفلونزا (D) وفيروس كورونا الكلبي قد يشكلان تهديدا صحيا عالميا في حال استمرار ضعف المراقبة والتشخيص، ما قد يهيئ الظروف لانتشارهما بين البشر على نطاق واسع.
وأوضحت الدراسة أن هذين الفيروسين يمتلكان خصائص تؤهلهما للتطور السريع والتسبب في تفشيات وبائية، في ظل محدودية الجهود المبذولة لرصدهما والوقاية منهما.
وقال الباحث المشارك، الدكتور جون ليدنيكي من جامعة فلوريدا، إن مراجعة الأبحاث المنشورة أظهرت أن الفيروسين يشكلان تهديدا مباشرا للجهاز التنفسي لدى البشر، مضيفا أن الاستجابة العلمية والوقائية لهما ما تزال محدودة. وأشار إلى أن اكتسابهما القدرة على الانتقال السهل بين الأشخاص قد يؤدي إلى أوبئة أو جوائح، نظرا لغياب المناعة المجتمعية ضدهما.
وبيّنت الدراسة أن فيروس الإنفلونزا (D)، الذي اكتُشف عام 2011، ارتبط في البداية بإصابات الخنازير والأبقار، قبل أن يُرصد في أنواع أخرى من الحيوانات البرية والداجنة، مثل الغزلان والزرافات والكنغر والدواجن. ويُعتقد أن هذا الفيروس يساهم في أمراض تنفسية لدى الأبقار، تكبّد صناعة الماشية في الولايات المتحدة خسائر تُقدّر بنحو مليار دولار سنويا.
وكشفت أبحاث سابقة أُجريت على عمال الماشية في ولايتي كولورادو وفلوريدا أن نحو 97% منهم يحملون أجساما مضادة للفيروس، ما يدل على تعرضهم له دون ظهور أعراض واضحة. ويؤكد الباحثون امتلاك الفيروس قدرة عالية على التطور، خاصة بعد رصد سلالة في الصين قادرة على الانتقال بين البشر.
وفيما يتعلق بفيروس كورونا الكلبي، أشار الباحثون إلى تسجيل إصابات بشرية محدودة به، دون وجود فحوصات روتينية للكشف عنه، ما يجعل حجم انتشاره الحقيقي غير معروف.
وأوضح ليدنيكي أن هذا النقص في التشخيص قد يؤدي إلى التقليل من خطورته.
ويسبب فيروس كورونا الكلبي عادة أمراضا معوية لدى الكلاب، ويختلف عن الفيروس المسبب لـ”كوفيد-19″، إلا أن حالات نادرة في جنوب شرق آسيا ربطته بإصابات بشرية خطيرة والتهاب رئوي استدعى دخول المستشفى.
وفي عام 2021، تمكّن فريق من جامعة فلوريدا من عزل سلالة من هذا الفيروس من أحد أفراد الطاقم الطبي بعد عودته من هايتي، وأُطلق عليها اسم HuCCoV_Z19Haiti. وفي العام نفسه، أعلن باحثون من جامعة تكساس اكتشاف سلالة أخرى باسم CCoV-HuPn-2018 لدى طفل في ماليزيا، كانت متطابقة تقريبا مع السلالة الأولى.
ومنذ ذلك الوقت، جرى رصد هذه السلالة في تايلاند وفيتنام وولاية أركنساس الأمريكية، ما يؤكد قدرتها على الانتشار عبر القارات.
وأكد الباحثون أن هذه التطورات تعيد إلى الأذهان دروس الأوبئة السابقة، مشددين على أن غياب الاستعداد والجاهزية قد يسمح لفيروسات ناشئة بالتحول إلى أوبئة واسعة الانتشار. ودعوا إلى تعزيز أنظمة المراقبة الصحية، وتطوير وسائل التشخيص، وتسريع جهود البحث لإنتاج علاجات ولقاحات محتملة.
وختمت الدراسة بالتأكيد على أن المعرفة الحالية بوبائيات هذه الفيروسات وأعراضها السريرية ما تزال محدودة، غير أن المعطيات المتوافرة تشير إلى أنها تمثل تهديدا حقيقيا للصحة العامة.
نشرت الدراسة في مجلة “الأمراض المعدية الناشئة”.
المصدر: ميديكال إكسبريس












